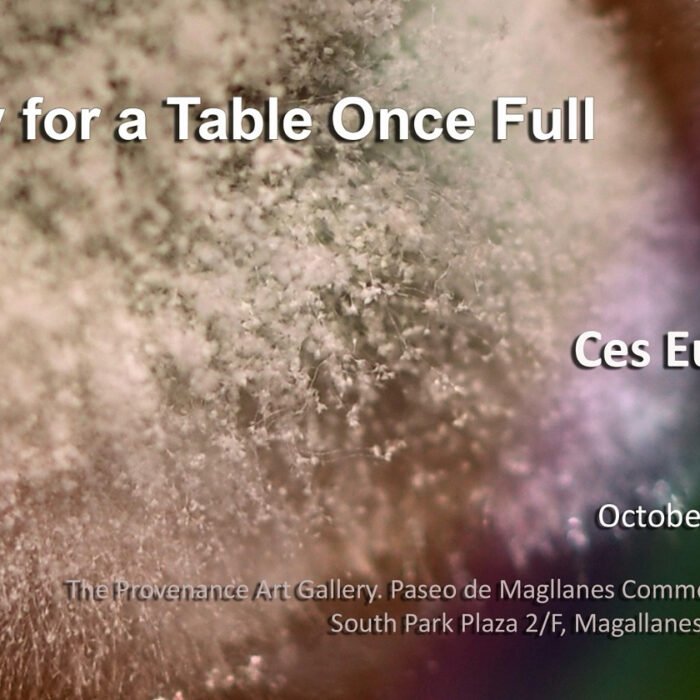

FEATURED EXHIBITIONS

Things Remembered

What Remains

“A Future in the Past”

Two-fold Playground and Opposite Mirrors

Subtle Thoughts

Where Strides Begin
Elegy for a Table Once Full

Elysium in the Meadow

Bridging the gap

Drawn From Within

WANDERER IN THE LABYRINTH

Vita

A tale of views

I walk around in my head somewhere else


